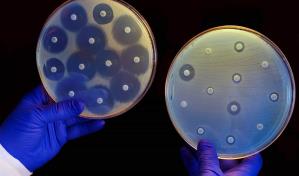

Versión Impresa
Secciones
Servicios
Más
Redes Sociales
Utilizamos cookies propias y de terceros para obtener datos estadísticos de la navegación de nuestros usuarios y mejorar nuestros servicios. Esto nos permite personalizar el contenido que ofrecemos y mostrar publicidad relacionada a sus intereses. Si continúa navegando, consideramos que acepta su uso.